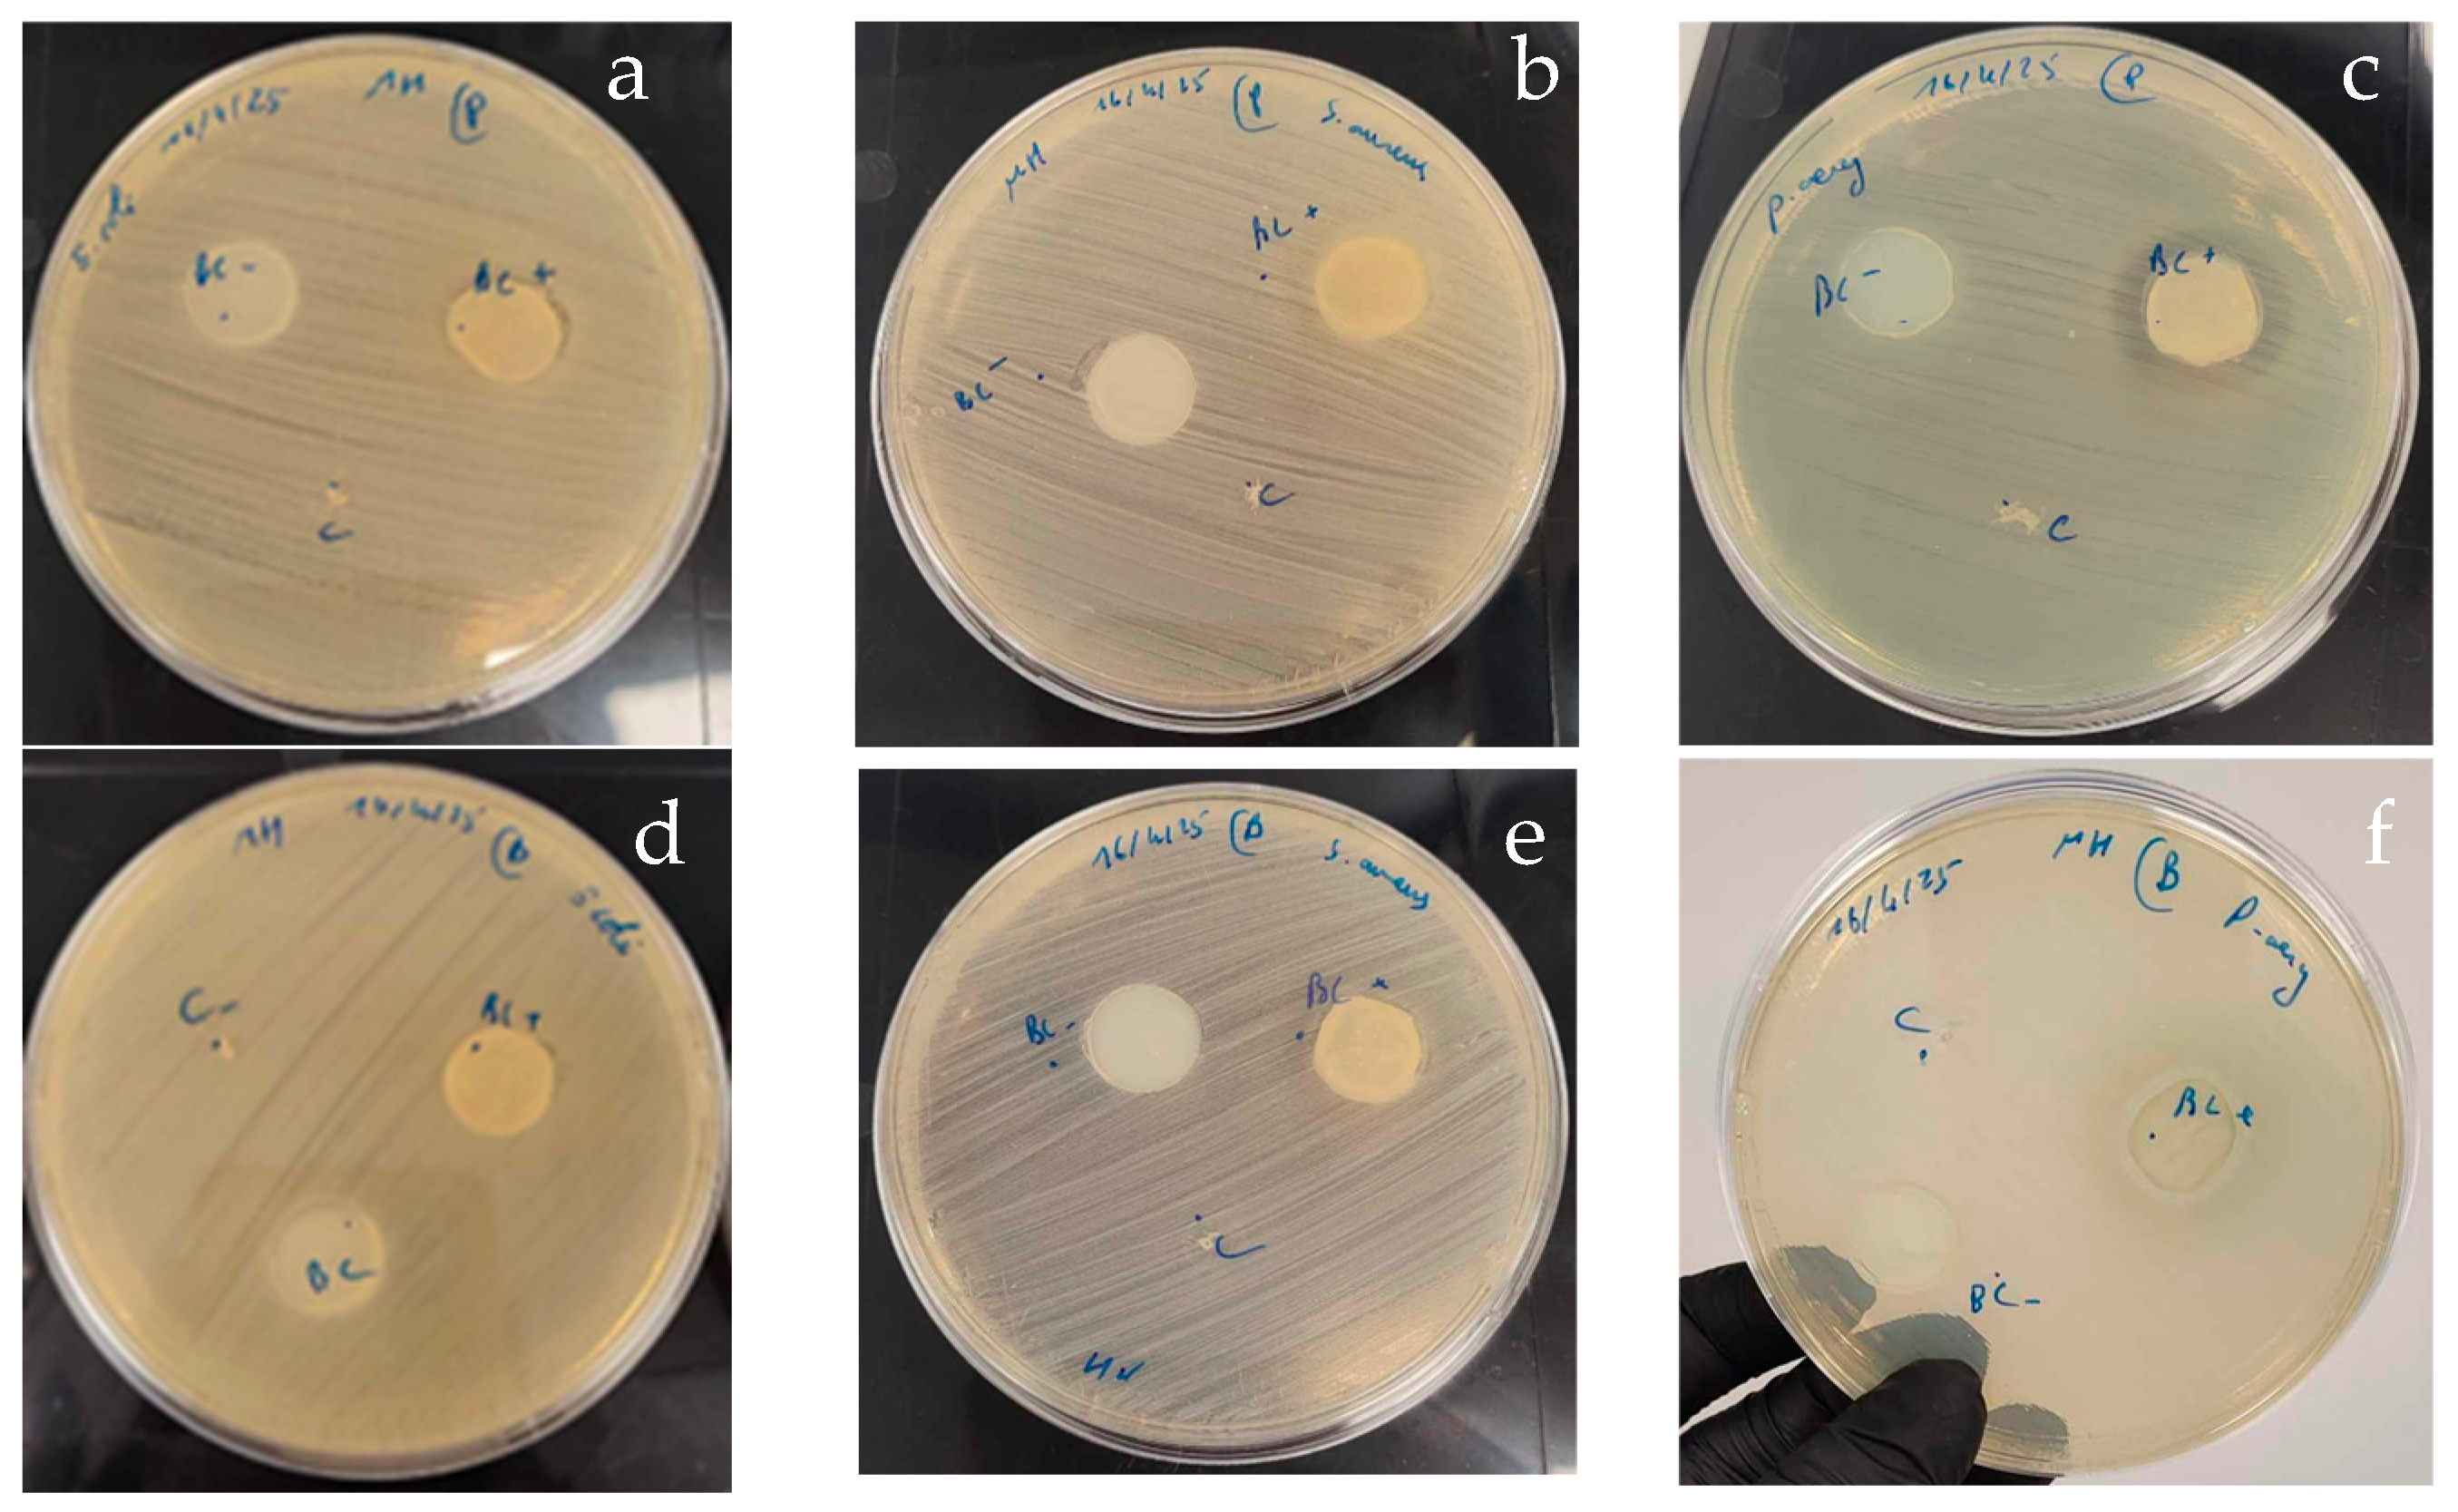
Foods 14 02853 g010 Foods 14 02853 g010

Bioconversion of Date Waste into Bacterial Nanocellulose by a New Isolate Komagataeibacter sp. IS22 and Its Use as Carrier Support for Probiotics Delivery
Abstract
1. Introduction
2. Materials and Methods
2.1. Sample Collection and Microbial Strains
2.2. Culture Media
2.3. Screening and Isolation of Cellulose-Producing Bacteria
2.4. Identification of Cellulose-Producing Bacteria
2.5. Analysis of BNC Pellicles
2.5.1. Structural Analysis: Fourier Transform Infrared Spectroscopy
2.5.2. Thermogravimetric Analysis
2.5.3. Scanning Electron Microscopy
2.6. Evaluation of Different Date Extracts for BNC Production
2.7. Optimization of BNC Production Using Full Factorial Design
2.8. Immobilization of Probiotic Strains into BNC Matrix
2.8.1. Co-Culture
2.8.2. Enumeration of Probiotic Cells
2.8.3. Evaluation of Antibacterial Activity of BNC-Probiotic Composites
2.9. Statistical Analysis
3. Results and Discussion
3.1. Isolation and Identification of Cellulose-Producing Bacteria
| Komagataeibacter sp. IS22 | Komagataeibacter sp. IS20 | Komagataeibacter sucrofermentans BPR 2001T (AJ007698.1) [30] | Komagataeibacter xylinus LMG 1515T (X75619.1) [31] | Komagataeibacter sp. IS21 | Komagataeibacter oboediens LTH2460T (AJ001631.1) [32] | Komagataeibacter medellensis LMG 1693T (JX013852.1) [33] | Komagataeibacter intermedius LMG 18909T (Y14694.1) [34] | |
|---|---|---|---|---|---|---|---|---|
| 16S rRNA similarity with IS22 (%) | 100 | 99.30 | 99.48 | 99.26 | 98.68 | 99.04 | 98.74 | 99.04 |
| 16S rRNA similarity with IS20 (%) | 99.30 | 100 | 99.76 | 99.45 | 99.21 | 99.21 | 98.98 | 99.21 |
| 16S rRNA similarity with IS21 (%) | 98.68 | 99.21 | 99.14 | 98.98 | 100 | 99.53 | 99.30 | 99.53 |
| Morphology | rod shaped | rod shaped | rod shaped | rod shaped | rod shaped | rod shaped | rod shaped | rod shaped |
| Gram staining | − | − | − | − | − | − | − | − |
| Catalase | + | + | + | + | + | + | + | + |
| Oxidase | − | − | − | − | − | − | − | − |
| Brown pigment production | − | − | − | − | − | − | − | − |
| Indole | − | − | NR | NR | − | NR | NR | NR |
| Voges Proskauer | + | − | NR | NR | + | NR | NR | NR |
| Urease test | − | − | NR | NR | − | NR | NR | NR |
| Citrate utilization | − | − | NR | NR | − | NR | NR | NR |
| Gelatin liquefaction | − | − | NR | NR | − | NR | NR | NR |
| Hydrogen sulfide production | − | − | NR | NR | − | NR | NR | NR |
| Ornithine decarboxylase | − | − | NR | NR | − | NR | NR | NR |
| Nitrate reduction | − | − | NR | NR | − | NR | NR | NR |
| Overoxidation of Ethanol | + | + | + | NR | + | + | + | + |
| Motility | − | − | − | − | − | − | − | − |
| BNC Production yield (g/L) | 1.8 | 1.7 | 1.72 [35] | 1.83 [36] | 0,8 | No | No | 5.93 [37] |
| Acid production from | ||||||||
| Glucose | + | + | + | + | + | + | + | NR |
| Sucrose | − | − | + | + | − | + | + | NR |
| Glycerol | + | + | + | + | + | + | NR | NR |
| Mannitol | − | − | NR | NR | − | − | + | NR |
| Mannose | − | − | NR | NR | − | NR | NR | NR |
| Inositol | − | − | NR | NR | − | NR | NR | NR |
| Sorbitol | − | − | NR | NR | − | − | + | NR |
| Rhamnose | − | − | NR | NR | + | NR | NR | NR |
| Melibiose | + | + | NR | NR | + | NR | NR | NR |
| Amygdaline | − | − | NR | NR | − | NR | NR | NR |
| Arabinose | + | + | NR | NR | + | NR | NR | NR |
3.2. Characterization of BNC Pellicles
3.2.1. Fourier Transform Infrared Spectroscopy
3.2.2. Thermal Properties: Thermogravimetric Analysis
3.2.3. Microstructure: Scanning Electron Microscopy
3.3. Screening of Date Waste Extracts for BNC Production
3.4. Optimization of BNC Production Using Full Factorial Design (FFD)
| Source | DF | Adj SS | Adj MS | F-Value | p-Value |
|---|---|---|---|---|---|
| Model | 5 | 9.5568 | 1.91135 | 32.50 | 0.030 |
| Linear | 3 | 5.8386 | 1.94621 | 33.09 | 0.029 |
| X1 | 1 | 3.4716 | 3.47161 | 59.03 | 0.017 |
| X2 | 1 | 2.0100 | 2.01001 | 34.18 | 0.028 |
| X3 | 1 | 0.3570 | 0.35701 | 6.07 | 0.133 |
| 2-Way Interactions | 2 | 3.7181 | 1.85906 | 31.61 | 0.031 |
| X1 × X2 | 1 | 3.2131 | 3.21311 | 54.63 | 0.018 |
| X1 × X3 | 1 | 0.5050 | 0.50501 | 8.59 | 0.099 |
| Error | 2 | 0.1176 | 0.05881 | ||
| Total | 7 | 9.6744 |

3.5. Application of BNC as Probiotic Carrier
3.5.1. Viability of Immobilized Probiotic Cells
3.5.2. Antibacterial Activity of BNC-Probiotic Composites
4. Conclusions
Author Contributions
Funding
Institutional Review Board Statement
Informed Consent Statement
Data Availability Statement
Conflicts of Interest
References
- Gregory, D.A.; Tripathi, L.; Fricker, A.T.R.; Asare, E.; Orlando, I.; Raghavendran, V.; Roy, I. Bacterial cellulose: A smart biomaterial with diverse applications. Mater. Sci. Eng. R. Rep. 2021, 145, 100623. [Google Scholar] [CrossRef]
- Sulaeva, I.; Henniges, U.; Rosenau, T.; Potthast, A. Bacterial cellulose as a material for wound treatment: Properties and modifications: A review. Biotechnol. Adv. 2015, 33, 1547–1571. [Google Scholar] [CrossRef] [PubMed]
- Yan, Z.; Chen, S.; Wang, H.; Wang, B.; Jiang, J. Biosynthesis of bacterial cellulose/multi-walled carbon nanotubes in agitated culture. Carbohydr. Polym. 2008, 74, 659–665. [Google Scholar] [CrossRef]
- Shi, Z.; Zhang, Y.; Phillips, G.O.; Yang, G. Utilization of bacterial cellulose in food. Food Hydrocoll. 2014, 35, 539–545. [Google Scholar] [CrossRef]
- Okiyama, A.; Motoki, M.; Yamanaka, S. Bacterial cellulose IV. Application to processed foods. Food Hydrocoll. 1993, 6, 503–511. [Google Scholar] [CrossRef]
- Pacheco, G.; de Mello, C.V.; Chiari-Andréo, B.G.; Isaac, V.L.B.; Ribeiro, S.J.L.; Pecoraro, É.; Trovatti, E. Bacterial cellulose skin masks—Properties and sensory tests. J. Cosmet. Dermatol. 2018, 17, 840–847. [Google Scholar] [CrossRef]
- Jiang, Y. Wang, Z., Liu, Y., Zhang, Z., Eds.; Forced hydrolysis and chemical co-precipitation. In Handbook of Nanophase and Nanostructured Materials; Springer: Boston, MA, USA, 2003; Volume 1, pp. 55–71. [Google Scholar]
- Portela, R.; Leal, C.R.; Almeida, P.L.; Sobral, R.G. Bacterial cellulose: A versatile biopolymer for wound dressing applications. Microb. Biotechnol. 2019, 12, 586–610. [Google Scholar] [CrossRef]
- Nguyen, V.T.; Flanagan, B.; Gidley, M.J.; Dykes, G.A. Characterization of cellulose production by a Gluconacetobacter xylinus strain from Kombucha. Curr. Microbiol. 2008, 57, 449–453. [Google Scholar] [CrossRef]
- Pourramezan, Z.; Ardakani, M.R.; Reza, G.G. Isolation and Characterization of Cellulose—Producing Bacteria from Local Samples of Iran. Int. J. Microbiol. Res. 2011, 2, 240–242. [Google Scholar]
- Jahan, F.; Kumar, V.; Rawat, G.; Saxena, R.K. Production of microbial cellulose by a bacterium isolated from fruit. Appl. Biochem. Biotechnol. 2012, 167, 1157–1171. [Google Scholar] [CrossRef]
- Suwanposri, A.; Yukphan, P.; Yamada, Y.; Ochaikul, D. Identification and biocellulose production of Gluconacetobacter strains isolated from tropical fruits in Thailand. Maejo Int. J. Sci. Technol. 2013, 7, 70–82. [Google Scholar]
- Leonarski, E.; Cesca, K.; Pinto, C.C.; González, S.Y.G.; de Oliveira, D.; Poletto, P. Bacterial cellulose production from acerola industrial waste using isolated kombucha strain. Cellulose 2022, 29, 7613–7627. [Google Scholar] [CrossRef]
- Güzel, M.; Akpınar, Ö. Production and characterization of bacterial cellulose from citrus peels. Waste Biomass Valorization 2019, 10, 2165–2175. [Google Scholar] [CrossRef]
- El-Bestawy, E.; Eltaweil, A.S.; Khallaf, N.S. Effective production of bacterial cellulose using acidic dairy industry by-products and agro wastes. Sustain. Chem. Pharm. 2023, 33, 101064. [Google Scholar] [CrossRef]
- Qiao, N.; Fan, X.; Zhang, X.; Shi, Y.; Wang, L.; Yu, D. Soybean oil refinery effluent treatment and its utilization for bacterial cellulose production by Gluconacetobacter xylinus. Food Hydrocoll. 2019, 97, 105185. [Google Scholar] [CrossRef]
- Efthymiou, M.-N.; Tsouko, E.; Pateraki, C.; Papagiannopoulos, A.; Tzamalis, P.; Pispas, S.; Bethanis, K.; Mantala, I.; Koutinas, A. Property evaluation of bacterial cellulose nanostructures produced from confectionery wastes. Biochem. Eng. J. 2022, 186, 108575. [Google Scholar] [CrossRef]
- Barreveld, W.H. Date Palm Products. In FAO Agricultural Service Bulletin No. 101; Food and Agriculture Organization of the United Nations: Rome, Italy, 1993. [Google Scholar]
- Sayah, I.; Njehi, M.; Cicero, N.; Nava, V.; Ben M’hadheb, M.; Majdoub, H.; Achour, S.; Gervasi, T. Optimization of Sugar Extraction Process from Date Waste Using Full Factorial Design Toward Its Use for New Biotechnological Applications. BioTech 2024, 13, 39. [Google Scholar] [CrossRef]
- Hestrin, S.; Schramm, M. Synthesis of cellulose by Acetobacter xylinum. II. Preparation of freeze-dried cells capable of polymerizing glucose to cellulose. Biochem. J. 1954, 58, 345–352. [Google Scholar] [CrossRef]
- Kaur, L.; Shah, S. Screening and Characterization of Cellulose-Producing Bacterial Strains from Decaying Fruit Waste. Inter. J. Food Nutr. Sci. 2022, 11, 8–14. [Google Scholar]
- Boone, D.R.; Castenholz, R.W.; Garrity, G.M.; Brenner, D.J.; Krieg, N.R.; Staley, J.T. Bergey’s Manual® of Systematic Bacteriology; Springer Science & Business Media; Springer: Berlin, Germany, 2001; Volume 2. [Google Scholar]
- Wang, S.-S.; Han, Y.-H.; Ye, Y.-X.; Shi, X.-X.; Xiang, P.; Chen, D.-L.; Li, M. Physicochemical characterization of high-quality bacterial cellulose produced by Komagataeibacter sp. strain W1 and identification of the associated genes in bacterial cellulose production. RSC Adv. 2017, 7, 45145–45155. [Google Scholar] [CrossRef]
- Tamura, K.; Stecher, G.; Kumar, S. MEGA11: Molecular Evolutionary Genetics Analysis Version 11. Mol. Biol. Evol. 2021, 38, 3022–3027. [Google Scholar] [CrossRef]
- Nelson, M.L.; O’Connor, R.T. Relation of certain infrared bands to cellulose crystallinity and crystal lattice type. Part II. A new infrared ratio for estimation of crystallinity in celluloses I and II. J. Appl. Polym. Sci. 1964, 8, 1325–1341. [Google Scholar] [CrossRef]
- Sabio, L.; González, A.; Ramírez-Rodríguez, G.B.; Gutiérrez-Fernández, J.; Bañuelo, O.; Olivares, M.; Gálvez, N.; Delgado-López, J.M.; Dominguez-Vera, J.M. Probiotic cellulose: Antibiotic-free biomaterials with enhanced antibacterial activity. Acta Biomater. 2021, 124, 244–253. [Google Scholar] [CrossRef] [PubMed]
- Park, J.K.; Jung, J.Y.; Park, Y.H. Cellulose production by Gluconacetobacter hansenii in a medium containing ethanol. Biotechnol. Lett. 2003, 25, 2055–2059. [Google Scholar] [CrossRef] [PubMed]
- Rangaswamy, B.E.; Vanitha, K.P.; Hungund, B.S. Microbial Cellulose Production from Bacteria Isolated from Rotten Fruit. Int. J. Polym. Sci. 2015, 2015, 280784. [Google Scholar] [CrossRef]
- Yang, X.-Y.; Huang, C.; Guo, H.-J.; Xiong, L.; Luo, J.; Wang, B.; Lin, X.-Q.; Chen, X.-F.; Chen, X.-D. Bacterial cellulose production from the litchi extract by Gluconacetobacter xylinus. Prep. Biochem. Biotechnol. 2016, 46, 39–43. [Google Scholar] [CrossRef]
- Toyosaki, H.; Kojima, Y.; Tsuchida, T.; Hoshino, K.I.; Yamada, W.; Yoshinaga, F. The characterization of an acetic acid bacterium useful for producing bacterial cellulose in agitation cultures: The proposal of Acetobacter xylinum subsp. Sucrofermentans subsp. nov. J. Gen. Appl. Microbiol. 1995, 41, 307–314. [Google Scholar] [CrossRef]
- Yamada, Y.; Kondo, K. Gluconoacetobacter, a new subgenus comprising the acetate-oxidizing acetic acid bacteria with ubiquinone-10 in the genus acetobacter. J. Gen. Appl. Microbiol. 1984, 30, 297–303. [Google Scholar] [CrossRef]
- Sokollek, S.J.; Hertel, C.; Hammes, W.P. Description of Acetobacter oboediens sp. nov. and Acetobacter pomorum sp. nov., two new species isolated from industrial vinegar fermentations. Int. J. Syst. Bacteriol. 1998, 48, 935–940. [Google Scholar] [CrossRef]
- Castro, C.; Cleenwerck, I.; Trček, J.; Zuluaga, R.; De Vos, P.; Caro, G.; Aguirre, R.; Putaux, J.-L.; Gañán, P. Gluconacetobacter medellinensis sp. nov., cellulose- and non-cellulose-producing acetic acid bacteria isolated from vinegar. Int. J. Syst. Evol. Microbiol. 2013, 63 Pt 3, 1119–1125. [Google Scholar] [CrossRef]
- Boesch, C.; Trček, J.; Sievers, M.; Teuber, M. Acetobacter intermedius, sp. nov. Syst. Appl. Microbiol. 1998, 21, 220–229. [Google Scholar] [CrossRef]
- Yilmaz, M.; Goksungur, Y. Optimization of Bacterial Cellulose Production from Waste Figs by Komagataeibacter xylinus. Fermentation 2024, 10, 466. [Google Scholar] [CrossRef]
- Vigentini, I.; Fabrizio, V.; Dellacà, F.; Rossi, S.; Azario, I.; Mondin, C.; Benaglia, M.; Foschino, R. Set-Up of Bacterial Cellulose Production From the Genus Komagataeibacter and Its Use in a Gluten-Free Bakery Product as a Case Study. Front. Microbiol. 2019, 10, 1953. [Google Scholar] [CrossRef] [PubMed]
- Fatima, A.; Ortiz-Albo, P.; Neves, L.A.; Nascimento, F.X.; Crespo, J.G. Biosynthesis and characterization of bacterial cellulose membranes presenting relevant characteristics for air/gas filtration. J. Memb. Sci. 2023, 674, 121509. [Google Scholar] [CrossRef]
- Pacheco, G.; Nogueira, C.R.; Meneguin, A.B.; Trovatti, E.; Silva, M.C.C.; Machado, R.T.A.; Ribeiro, S.J.L.; da Silva Filho, E.C.; Barud, H.d.S. Development and characterization of bacterial cellulose produced by cashew tree residues as alternative carbon source. Ind. Crops Prod. 2017, 107, 13–19. [Google Scholar] [CrossRef]
- Cerrutti, P.; Roldán, P.; García, R.M.; Galvagno, M.A.; Vázquez, A.; Foresti, M.L. Production of bacterial nanocellulose from wine industry residues: Importance of fermentation time on pellicle characteristics. J. Appl. Polym. Sci. 2016, 133, 43109. [Google Scholar] [CrossRef]
- Khan, H.; Raghuvanshi, S.; Saroha, V.; Singh, S.; Baba, W.N.; Mudgil, P.; Dutt, D. Biotransformation of banana peel waste into bacterial nanocellulose and its modification for active antimicrobial packaging using polyvinyl alcohol with in-situ generated silver nanoparticles. Food Packag. Shelf Life 2023, 38, 101115. [Google Scholar] [CrossRef]
- Hamed, D.A.; Maghrawy, H.H.; Abdel Kareem, H. Biosynthesis of bacterial cellulose nanofibrils in black tea media by a symbiotic culture of bacteria and yeast isolated from commercial kombucha beverage. World J. Microbiol. Biotechnol. 2023, 39, 48. [Google Scholar] [CrossRef]
- Amin, M.C.I.M.; Ahmad, N.; Halib, N.; Ahmad, I. Synthesis and characterization of thermo-and pH-responsive bacterial cellulose/acrylic acid hydrogels for drug delivery. Carbohydr. Polym. 2012, 88, 465–473. [Google Scholar] [CrossRef]
- Kumar, A.; Negi, Y.S.; Choudhary, V.; Bhardwaj, N.K. Characterization of cellulose nanocrystals produced by acid-hydrolysis from sugarcane bagasse as agro-waste. J. Mater. Phys. Chem. 2014, 2, 1–8. [Google Scholar] [CrossRef]
- Dáger-López, D.; Chenché, Ó.; Ricaurte-Párraga, R.; Núñez-Rodríguez, P.; Bajaña, J.M.; Fiallos-Cárdenas, M. Advances in the Production of Sustainable Bacterial Nanocellulose from Banana Leaves. Polymers 2024, 16, 1157. [Google Scholar] [CrossRef]
- Åkerholm, M.; Hinterstoisser, B.; Salmén, L. Characterization of the crystalline structure of cellulose using static and dynamic FT-IR spectroscopy. Carbohydr. Res. 2004, 339, 569–578. [Google Scholar] [CrossRef]
- Poletto, M.; Zattera, A.J.; Santana, R.M.C. Structural differences between wood species: Evidence from chemical composition, FTIR spectroscopy, and thermogravimetric analysis. J. Appl. Polym. Sci. 2012, 126 (Suppl. S1), E337–E344. [Google Scholar] [CrossRef]
- Popescu, C.M.; Singurel, G.; Popescu, M.C.; Vasile, C.; Argyropoulos, D.S.; Willför, S. Vibrational spectroscopy and X-ray diffraction methods to establish the differences between hardwood and softwood. Carbohydr. Polym. 2009, 77, 851–857. [Google Scholar] [CrossRef]
- Popescu, M.C.; Popescu, C.M.; Lisa, G.; Sakata, Y. Evaluation of morphological and chemical aspects of different wood species by spectroscopy and thermal methods. J. Mol. Struct. 2011, 988, 65–72. [Google Scholar] [CrossRef]
- Gomes, R.J.; Ida, E.I.; Spinosa, W.A. Nutritional Supplementation with Amino Acids on Bacterial Cellulose Production by Komagataeibacter intermedius: Effect Analysis and Application of Response Surface Methodology. Appl. Biochem. Biotechnol. 2022, 194, 5017–5036. [Google Scholar] [CrossRef]
- Cheng, K.C.; Catchmark, J.; Demirci, A. Enhanced production of bacterial cellulose under agitated condition and its material property analysis. In Proceedings of the American Society of Agricultural and Biological Engineers Annual International Meeting 2009 (ASABE 2009), Reno, Nevada, 21–24 June 2009; Volume 3, pp. 2003–2013. [Google Scholar]
- Skiba, E.A.; Shavyrkina, N.A.; Skiba, M.A.; Mironova, G.F.; Budaeva, V.V. Biosynthesis of Bacterial Nanocellulose from Low-Cost Cellulosic Feedstocks: Effect of Microbial Producer. Int. J. Mol. Sci. 2023, 24, 14401. [Google Scholar] [CrossRef]
- Gorgieva, S.; Jančič, U.; Cepec, E.; Trček, J. Production efficiency and properties of bacterial cellulose membranes in a novel grape pomace hydrolysate by Komagataeibacter melomenusus AV436T and Komagataeibacter xylinus LMG 1518. Int. J. Biol. Macromol. 2023, 244, 125368. [Google Scholar] [CrossRef]
- El-Gendi, H.; Salama, A.; El-Fakharany, E.M.; Saleh, A.K. Optimization of bacterial cellulose production from prickly pear peels and its ex situ impregnation with fruit byproducts for antimicrobial and strawberry packaging applications. Carbohydr. Polym. 2023, 302, 120383. [Google Scholar] [CrossRef]
- Heydorn, R.L.; Lammers, D.; Gottschling, M.; Dohnt, K. Effect of food industry by-products on bacterial cellulose production and its structural properties. Cellulose 2023, 30, 4159–4179. [Google Scholar] [CrossRef]
- Jacek, P.; da Silva, F.A.S.; Dourado, F.; Bielecki, S.; Gama, M. Optimization and characterization of bacterial nanocellulose produced by Komagataeibacter rhaeticus K3. Carbohydr. Polym. Technol. Appl. 2021, 2, 100022. [Google Scholar] [CrossRef]
- Ryngajłło, M.; Jacek, P.; Cielecka, I.; Kalinowska, H.; Bielecki, S. Effect of ethanol supplementation on the transcriptional landscape of bionanocellulose producer Komagataeibacter xylinus E25. Appl. Microbiol. Biotechnol. 2019, 103, 6673–6688. [Google Scholar] [CrossRef]
- Naritomi, T.; Kouda, T.; Yano, H.; Yoshinaga, F. Effect of lactate on bacterial cellulose production from fructose in continuous culture. J. Ferment. Bioeng. 1998, 85, 89–95. [Google Scholar] [CrossRef]
- Raiszadeh-Jahromi, Y.; Rezazadeh-Bari, M.; Almasi, H.; Amiri, S. Optimization of bacterial cellulose production by Komagataeibacter xylinus PTCC 1734 in a low-cost medium using optimal combined design. J. Food Sci. Technol. 2020, 57, 2524–2533. [Google Scholar] [CrossRef] [PubMed]
- Hasanin, M.S.; Abdelraof, M.; Hashem, A.H.; El Saied, H. Sustainable bacterial cellulose production by Achromobacter using mango peel waste. Microb. Cell Fact. 2023, 22, 24. [Google Scholar] [CrossRef] [PubMed]
- Rani, M.U.; Appaiah, A. Optimization of culture conditions for bacterial cellulose production from Gluconacetobacter hansenii UAC09. Ann. Microbiol. 2011, 61, 781–787. [Google Scholar] [CrossRef]
- Fijałkowski, K.; Peitler, D.; Rakoczy, R.; Zywicka, A. Survival of probiotic lactic acid bacteria immobilized in different forms of bacterial cellulose in simulated gastric juices and bile salt solution. LWT 2016, 68, 322–328. [Google Scholar] [CrossRef]
- Vuotto, C.; Longo, F.; Donelli, G. Probiotics to counteract biofilm-associated infections: Promising and conflicting data. Int. J. Oral. Sci. 2014, 6, 189–194. [Google Scholar] [CrossRef]
- Guandalini, S.; Pensabene, L.; Zikri, M.A.; Dias, J.A.; Casali, L.G.; Hoekstra, H.; Kolacek, S.; Massar, K.; Micetic-Turk, D.; Papadopoulou, A.; et al. Lactobacillus GG administered in oral rehydration solution to children with acute diarrhea: A multicenter European trial. J. Pediatr. Gastroenterol. Nutr. 2020, 30, 54–60. [Google Scholar]
- Chapman, T.M.; Plosker, G.L.; Figgitt, D.P. VSL#3 probiotic mixture: A review of its use in chronic inflammatory bowel diseases. Drugs 2006, 66, 1371–1387. [Google Scholar]
- Guo, Q.; Goldenberg, G.Z.; Hunphrey, C.; El Dib, R.; Johnston, B.C. Probiotics for the prevention of pediatric antibiotic-associated diarrhea. Cochrane Database Syst. Rev. 2019, 4, CD004827. [Google Scholar] [CrossRef]
- Wall, G.C.; Schirmer, L.L.; Anliker, L.E.; Tigges, A.E. Pharmacotherapy for Acute Pouchitis. Ann. Pharmacother. 2011, 45, 1127–1137. [Google Scholar] [CrossRef]
- Jagannath, A.; Raju, P.S.; Bawa, A.S. Comparative evaluation of bacterial cellulose (nata) as a cryoprotectant and carrier support during the freeze drying process of probiotic lactic acid bacteria. LWT 2010, 43, 1197–1203. [Google Scholar] [CrossRef]
- Phromthep, K.; Leenanon, B. Survivability of immobilized Lactobacillus plantarum cells within bacterial cellulose in mamao juice. Int. Food Res. J. 2017, 24, 939–949. [Google Scholar]
- Jayani, T.; Sanjeev, B.; Marimuthu, S.; Uthandi, S. Bacterial Cellulose Nano Fiber (BCNF) as carrier support for the immobilization of probiotic, Lactobacillus acidophilus 016. Carbohydr. Polym. 2020, 250, 116965. [Google Scholar] [CrossRef] [PubMed]
- Drachuk, I.; Harbaugh, S.; Geryak, R.; Kaplan, D.L.; Tsukruk, V.V.; Kelley-Loughnane, N. Immobilization of Recombinant, E. coli Cells in a Bacterial Cellulose-Silk Composite Matrix to Preserve Biological Function. ACS Biomater. Sci. Eng. 2017, 3, 2278–2292. [Google Scholar] [CrossRef]
- Gutiérrez-Fernández, J.; Cerezo-Collado, L.; Garcés, V.; Alarcón-Guijo, P.; Delgado-López, J.M.; Dominguez-Vera, J.M. Probiotic-Loaded Bacterial Cellulose as an Alternative to Combat Carbapenem-Resistant Bacterial Infections. Antibiotics 2024, 13, 1003. [Google Scholar] [CrossRef] [PubMed]
- Savitskaya, I.S.; Shokatayeva, D.H.; Kistaubayeva, A.S.; Ignatova, L.V.; Digel, I.E. Antimicrobial and wound healing properties of a bacterial cellulose based material containing B. subtilis cells. Heliyon 2019, 5, e02592. [Google Scholar] [CrossRef]
- Lappa, I.K.; Kachrimanidou, V.; Alexandri, M.; Papadaki, A.; Kopsahelis, N. Novel probiotic/bacterial cellulose biocatalyst for the development of functional dairy beverage. Foods 2022, 11, 2586. [Google Scholar] [CrossRef]
- Motalebi Moghanjougi, Z.; Rezazadeh Bari, M.; Alizadeh Khaledabad, M.; Almasi, H.; Amiri, S. Bio-preservation of white brined cheese (Feta) by using probiotic bacteria immobilized in bacterial cellulose: Optimization by response surface method and characterization. LWT 2020, 117, 108603. [Google Scholar] [CrossRef]
- Ntsefong, G.N.; Lodygin, A.; Evdokimov, I.; Oboturova, N.; Rzhepakovsky, I.; Nersesyan, T.; Povetkin, S.; Nagdalian, A. Polymer selection for microencapsulation of probiotics: Impact on viability, stability, and delivery in functional foods for improved manufacturing and product development in the food industry. Slovak J. Food Sci. 2023, 17, 712–727. [Google Scholar] [CrossRef]

| Runs | X1 | X2 | X3 | Experimental | Predicted |
|---|---|---|---|---|---|
| 1 | 5 (−1) | 2 (−1) | 2 (+1) | 4.53 | 4.66 |
| 2 | 10 (+1) | 4 (+1) | 2 (+1) | 6.59 | 6.48 |
| 3 | 10 (+1) | 2 (−1) | 2 (+1) | 4.08 | 4.21 |
| 4 | 5 (−1) | 2 (−1) | 1 (−1) | 3.85 | 3.74 |
| 5 | 10 (+1) | 2 (−1) | 1 (−1) | 4.4 | 4.29 |
| 6 | 5 (−1) | 4 (+1) | 1 (−1) | 3.34 | 3.47 |
| 7 | 10 (+1) | 4 (+1) | 1 (−1) | 6.43 | 6.56 |
| 8 | 5 (−1) | 4 (+1) | 2 (+1) | 4.51 | 4.40 |
| Samples | TCI | LOI | HBI |
|---|---|---|---|
| H1372/H2900 | H1429/H897 | A3400/A1320 | |
| IS20 | 0.999799 | 0.994601 | 0.996281 |
| IS21 | 1.000803 | 0.9976 | 0.999198 |
| IS22 | 0.996679 | 0.991493 | 0.992936 |
| Culture Media | BNC Yield (g/L) |
|---|---|
| HS | 1.8 ± 0.25 |
| HS + AE | 2.81 ± 0.11 |
| HS + KE | 2.6 ± 0.08 |
| AE | 0.48 ± 0.01 |
| KE | 0.55 ± 0.01 |
Disclaimer/Publisher’s Note: The statements, opinions and data contained in all publications are solely those of the individual author(s) and contributor(s) and not of MDPI and/or the editor(s). MDPI and/or the editor(s) disclaim responsibility for any injury to people or property resulting from any ideas, methods, instructions or products referred to in the content. |
© 2025 by the authors. Licensee MDPI, Basel, Switzerland. This article is an open access article distributed under the terms and conditions of the Creative Commons Attribution (CC BY) license (https://creativecommons.org/licenses/by/4.0/).
Share and Cite
Sayah, I.; Chakroun, I.; Gervasi, C.; Barreca, D.; Lanteri, G.; Iannazzo, D.; Celesti, C.; Santini, A.; Achour, S.; Gervasi, T. Bioconversion of Date Waste into Bacterial Nanocellulose by a New Isolate Komagataeibacter sp. IS22 and Its Use as Carrier Support for Probiotics Delivery. Foods 2025, 14, 2853. https://doi.org/10.3390/foods14162853
Sayah I, Chakroun I, Gervasi C, Barreca D, Lanteri G, Iannazzo D, Celesti C, Santini A, Achour S, Gervasi T. Bioconversion of Date Waste into Bacterial Nanocellulose by a New Isolate Komagataeibacter sp. IS22 and Its Use as Carrier Support for Probiotics Delivery. Foods. 2025; 14(16):2853. https://doi.org/10.3390/foods14162853
Chicago/Turabian StyleSayah, Islam, Ibtissem Chakroun, Claudio Gervasi, Davide Barreca, Giovanni Lanteri, Daniela Iannazzo, Consuelo Celesti, Antonello Santini, Sami Achour, and Teresa Gervasi. 2025. "Bioconversion of Date Waste into Bacterial Nanocellulose by a New Isolate Komagataeibacter sp. IS22 and Its Use as Carrier Support for Probiotics Delivery" Foods 14, no. 16: 2853. https://doi.org/10.3390/foods14162853
APA StyleSayah, I., Chakroun, I., Gervasi, C., Barreca, D., Lanteri, G., Iannazzo, D., Celesti, C., Santini, A., Achour, S., & Gervasi, T. (2025). Bioconversion of Date Waste into Bacterial Nanocellulose by a New Isolate Komagataeibacter sp. IS22 and Its Use as Carrier Support for Probiotics Delivery. Foods, 14(16), 2853. https://doi.org/10.3390/foods14162853












